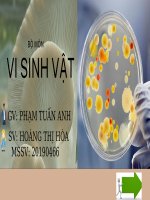
Giá trị dinh dưỡng của nấm trong cntp

Giá trị dinh dưỡng của nấm
Bạn đang xem bản rút gọn của tài liệu. Xem và tải ngay bản đầy đủ của tài liệu tại đây (707.42 KB, 6 trang )
GIÁ TRỊ DINH DƯỠNG CỦA NẤM
Chứa protein cao hơn các loại thực phẩm khác.
VD: Protein trong nấm sò: 30
Ptotein trong trứng gà: 13
Cung cấp nhiều vitamin thể như B2, B12,…
Cung cấp nhiều chất khoáng cho cơ thể
như: canxi, kali, sắt, Selenium,…
Hầu như không chất béo và Cholesterol
Nấm là thực phẩm ít calo, trung bình từ 22-35 calo
trên 100 gram nấm tươi
Vd: 100 gram Nấm Rơm tươi chứa 22-31 calories.
100 gram Nấm Bào Ngư tươi chứa 31-35 calories.
Cung cấp chất xơ cho cơ thể
Vd: 100 gram Nấm Rơm tươi chứa 1.1% chất xơ và
Nấm Rơm khô chứa 21 gram chất xơ
Thành phần dinh dưỡng trong 1 số loại nấm
Nấm hương ( Khô)
Trong 100g nấm hương khô:
Năng lượng
274 kcal
Đạm
35 g
Canxi
184 mg
Sắt
35 mg
Chất béo 4.5 g
Chất xơ 17 g
Cholesterol
0
Phốt pho 605 mg
Vitamin B1
200 mcg
Vitamin B2
1.6 mg
...
Chất đạm 12,5g
Chất béo 1,6g
Can-xi 16mg
Kali 240mg
Sắt, 3,9
Các vitamin…
Nấm đông cô
Nguồn :
/>
Đạm
36,1 g
Canxi
131 mg
Sắt
188.5 mg
Chất béo 3.6 g
Chất xơ 6g
Cholesterol
0
Phốt pho 718 mg
...
Nấm mỡ ( Khô)
Nấm kim châm
Nguồn :
Trong khoảng 125g loại nấm này có:
24 calo
5g carb
1,8g chất xơ
1,7g protein
0,2g chất béo
0,07mg vitamin B6
4,6mg niacin (vitamin B3)
0,1mg riboflavin (vitamin B2)
0,15mg thiamine (vitamin B1)
31 microgam folate (vitamin B9
Nguồn:
100g cung cấp:
Nấm bào ngư
33 calo,
6% nhu cầu chất xơ,
10% nhu cầu vitamin B1,
27% nhu cầu vitamin B2,
31% nhu cầu vitamin B3,
26% nhu cầu vitamin B5,
8% nhu cầu vitamin B6,
7% nhu cầu vitamin D,
9% nhu cầu kali,
27% nhu cầu đồng,
16,5% nhu cầu sắt,
4,5% nhu cầu Magie,
Nguồn:
90% nước
10% còn lại gồm: 10 – 40% protein
2 – 8% chất béo
3 – 28% carbohydrate,
3-32% chất xơ
Nấm linh chi
Nguồn :
Ngoài những loại nấm đem lại giá trị dinh dưỡng cao thì vẫn có những loại
nấm gây độc
-Nấm chứa độc tố muscarin cholin gây rối loạn tiêu hóa và trụy tim mạch
- Chất myceto atropin gây rối loạn thần kinh
- Chất Muscarin thì các biểu hiện bị ngộ độc nhẹ hơn, thường chỉ là các rối loạn tiêu hóa, tăng tiết
nước bọt, ra mồ hôi nhiều.
- Độc tố phalin, khi ăn vào độc tố gây tử vong
Nấm độc tán trắng
(Amanita verna)
Nấm độc trắng hình nón
(Amanita virosa)
Nấm mũ khía nâu
xám
Nấm ơ tán trắng
phiến xanh